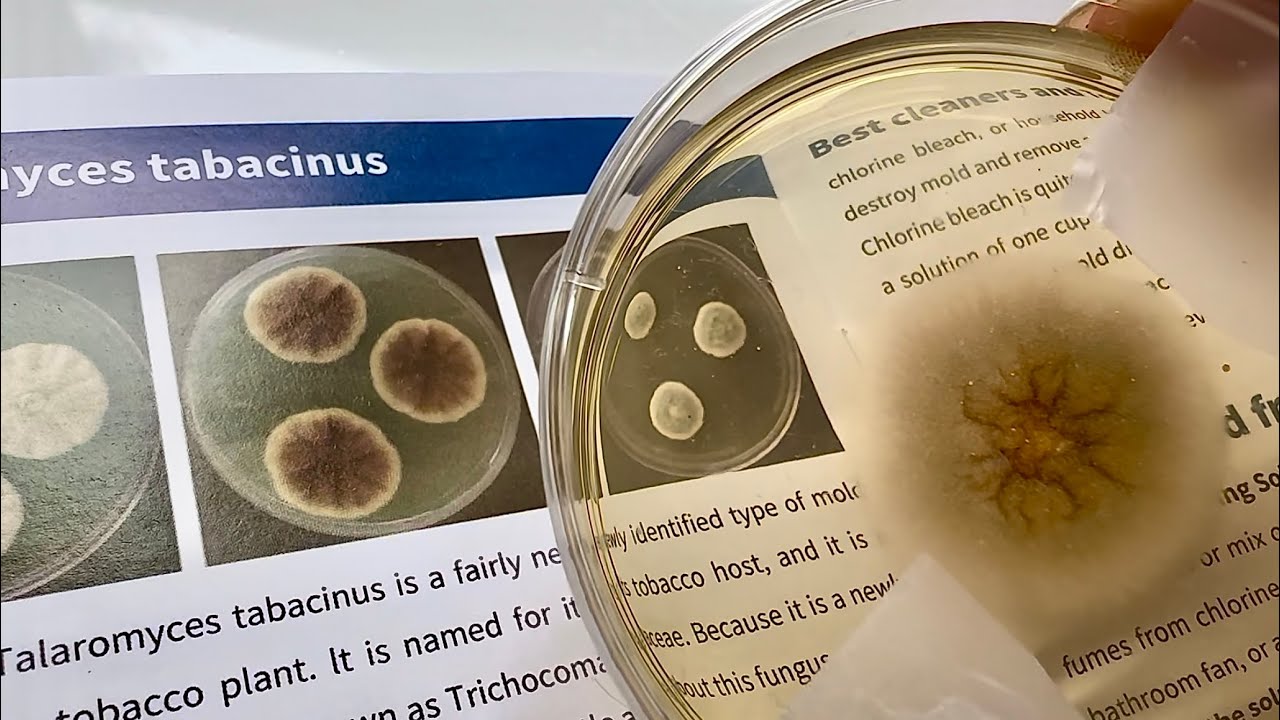
How to test for mold at home - DIY Mold Kit Tests Air, HVAC & Surfaces for Hidden Mold Fast! GGEPIAO

✅ Best indoor air quality monitor for mold: Indoor air quality monitor for mold (Buying Guide) скачать в хорошем качестве
Повторяем попытку...

Скачать видео с ютуб по ссылке или смотреть без блокировок на сайте: ✅ Best indoor air quality monitor for mold: Indoor air quality monitor for mold (Buying Guide) в качестве 4k
У нас вы можете посмотреть бесплатно ✅ Best indoor air quality monitor for mold: Indoor air quality monitor for mold (Buying Guide) или скачать в максимальном доступном качестве, видео которое было загружено на ютуб. Для загрузки выберите вариант из формы ниже:
-
Информация по загрузке:
Скачать mp3 с ютуба отдельным файлом. Бесплатный рингтон ✅ Best indoor air quality monitor for mold: Indoor air quality monitor for mold (Buying Guide) в формате MP3:
Если кнопки скачивания не
загрузились
НАЖМИТЕ ЗДЕСЬ или обновите страницу
Если возникают проблемы со скачиванием видео, пожалуйста напишите в поддержку по адресу внизу
страницы.
Спасибо за использование сервиса ClipSaver.ru
✅ Best indoor air quality monitor for mold: Indoor air quality monitor for mold (Buying Guide)
In this video, we're going to take a look at the best indoor air quality monitor for mold. We'll compare the best indoor air quality monitor for mold on the market and list their features and prices. 👇 Product Links 👇 1️⃣ BLUEAIR Mold Air Quality Monitor 🔥Amazon ➟ https://amzn.to/3JNqunZ 2️⃣ Airthings Mold Air Quality Monitor 🔥Amazon ➟ https://amzn.to/467770P 3️⃣ uHoo Mold Air Quality Monitor 🔥Amazon ➟ https://amzn.to/4p6LPsP 4️⃣ AQItech Mold Air Quality Monitor 🔥Amazon ➟ https://amzn.to/46icFqp 5️⃣ bonoch Mold Air Quality Monitor 🔥Amazon ➟ https://amzn.to/4lYNpKw 👇 Relevant Keywords 👇 air quality monitor india, airgradient, ikea air quality sensor, temtop air quality monitor, air quality monitor amazon, indoor air quality monitor, air quality monitor for home, best indoor air quality monitor, decibullz custom molded earphones, diy iem, indoor air quality monitor, amazon smart air quality monitor, mold remediation, dehumidifier, mold detector, mildew vs mold, moisture meter, moisture detector 👇 Disclaimer 👇 Portions of footage found in this video are not original content produced by “Gadgetech”. Portions of stock footage of products were gathered from multiple sources including amazon manufactures, fellow creators and various other sources. "All claims, guarantees and product specifications are provided by the manufacturer or vendor. “Gadgetech” cannot be held responsible for these claims, guarantees or specifications" (ad) “As An Amazon Associate, I Earn From Qualifying Purchases.” (Paid Link)